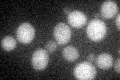
YGR277C
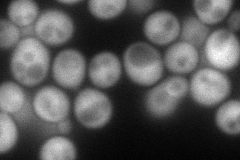
YGR277C
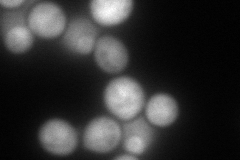
YGR277C
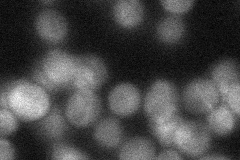
YGR277C
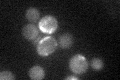
YGR277C

View description
Probable pantetheine-phosphate adenylyltransferase (PPAT), which catalyzes the fourth step in the biosynthesis of coenzyme A from pantothenate; null mutant lethality is complemented by E. coli coaD (encoding PPAT); widely conserved
Localization:
Intensity:
Fold change:
Significance:
-
C’ GFP library in SD
cytosol23.45 -
N' NOP1pr-GFP in SD
cytosol139.321 -
N' TEF2pr-mCherry in SD
cytosol169.438 -
N' NATIVEpr-GFP in SD
cytosol36.9111 -
N' TEF2pr-VC and Cyto-VN in SD

#N/A0 -
C’ GFP library in SD+DTT

cytosol28.681.22No -
C’ GFP library in SD+H2O2

cytosol29.461.25No -
C’ GFP library in Starvation Media
cytosol31.181.32No -
C’ GFP library on the background of Pup2-DaMP

cytosol -
C’ GFP library on the background of CCT mutant

cytosol24.6161.04965No
